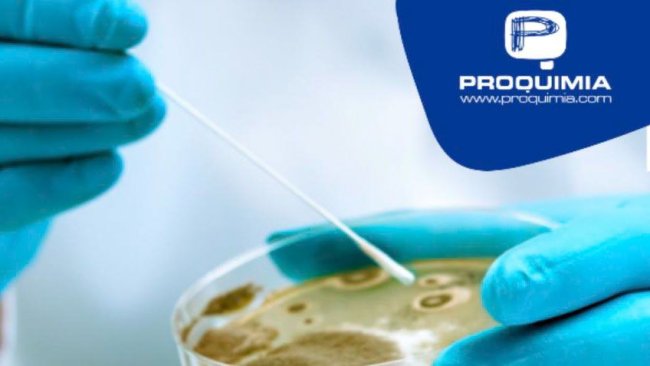

PROQUIMIA, S.A. ha obtenido la certificación de la norma IFS Global Markets HPC (Versión 1, Marzo 2018). Esta norma evalúa a los proveedores de productos de uso doméstico y del cuidado personal en relación con la calidad y la seguridad de productos y de procesos.
Concretamente, Proquimia ha obtenido la certificación con el siguiente alcance: Fabricación y envasado de productos químicos domésticos para la limpieza y/o desinfección, como: detergentes para la ropa, lavavajillas, limpiadores de superficies y suelos, descalcificadores, desodorantes de ambiente y limpiacristales. Así como productos químicos industriales para la limpieza, desinfección, tratamiento de superficies y tratamiento del agua. En envases de plástico (polietileno y PET), sacos de plástico (10, 15 y 25 kilos), big bags (1000 kilos), film hidrosoluble, bolsas ECOCONPACK, envases metálicos y bag in box e IBC. Además de la producción propia, la empresa subcontrata procesos y/o productos.

Con esta norma, Proquimia suma una nueva certificación a sus certificaciones actuales (ISO 9001, ISO 14001, ISO 45001), con el objetivo de ampliar su mercado local e internacional, formando parte del equipo IFS.
El objetivo de los distribuidores y fabricantes es la transparencia sobre toda su cadena de distribución internacional, por lo que IFS HPC cubre este aspecto, y sirve también como garantía para que los fabricantes suministren productos seguros y de calidad, desarrollando un proceso de mejora continua en todos los sistemas de gestión.

Mayo de 2021 - Proquimia